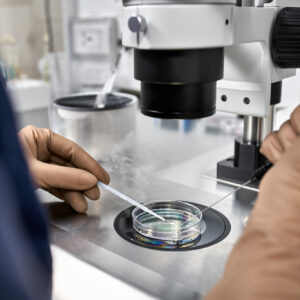
1 Hour Q&A on any topic

One on one
Donor Embryo Consult
$200.00
Full review of embryology report for those matched with donor embryos or considering embryo donation. Embryo quality, vit/thaw technique and device will be covered.
Review the Medical Advice Disclaimer Agreement

Reviews
There are no reviews yet.